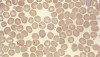
Babesiosis

Babesiosis

La babesiosis y la anaplasmosis son patologías que lo pueden confundir. Foto: Wikipedia
⦁ Cuando termina el verano y llegan las lluvias, los productores ganaderos sienten alivio porque ya hay comida para los animales. Generalmente, se acelera el crecimiento de los pastos, pero con ellos también aparecen los problemas.
Con la aparición de las lluvias se genera la proliferación de microorganismos que generan enfermedades infecciosas hemoparasitarias que afectan la salud animal. Estos males, no solo causan molestia en los bovinos, sino que también preocupan a los ganaderos por las implicaciones que tienen.
El médico veterinario Ernesto González afirma que el paso de la sequía al invierno es un originador de padecimientos como la babesiosis, en la que se presenta emisión de orina mezclada con hemoglobina, lo que ocasiona pérdida de producción, inclusive donde puede el animal competir con la vida si no se realiza un diagnóstico correcto y el tratamiento efectivo.
La anaplasmosis, es otro transtorno parasitario que afecta las células rojas de la sangre del bovino. De esta forma, se desarrolla en el animal una especie de anemia que lo debilita y le quita el apetito.
De acuerdo con González, estas dos enfermedades se pueden confundir por su sintomatología. Por ello, debe hacerse control de vectores (aspectos en común), pues los bovinos albergan el hemoparasito en sus glándulas salivales y al entrar en sangre, produce unas fuertes crisis que si no se trata a tiempo puede llevar a la muerte del animal.
Suele pensarse que estas patologías aparecen con el paso del verano al invierno. Sin embargo, se vuelven muy frecuentes en clima frio, pues generalmente se ocasionan por la picadura de moscos o plagas. En la babesiosis, la transmisión se realiza las garrapatas mientras que la anaplasmosis ocurre por mosquitos.
Asevera González que en las zonas de temperaturas cálidas, lo ideal es que durante la etapa de crecimiento el animal haya adquirido inmunidad frente a las garrapatas. Sin embargo, tratar de mantenerlos libres de estas plagas puede ser nocivo porque se aumenta su carga al momento de enfrentarse a las pasturas.
Cuando ya están establecidas las enfermedades, es importante realizar un control de garrapatas con productos como la ivermectina que tienen diferentes tiempos de acción según los laboratorios que los producen.
Recomiendan los expertos que al momento de realizar traslados de animales a zonas libre de estas, deben manejarse medidas preventivas y aplicar propionato de imidocarb, el cual al suministrarlo puede ocasionar picazón, pero protege al bovino mientras se habitúa a la zona.
Finalmente, indica González que es muy importante realizar el diagnostico mediante muestras de sangre de zonas periféricas del animal, más precisamente en la oreja o la cola para efectuar un cuadro hemático con exámenes de hemoparásitos y poder determinar, cuál de las dos enfermedades, babesiosis o anaplasmosis, es la que está generando el problema en el animal.
Fuente: Adaptado de CONtexto ganadero.
Con el patrocinio de: